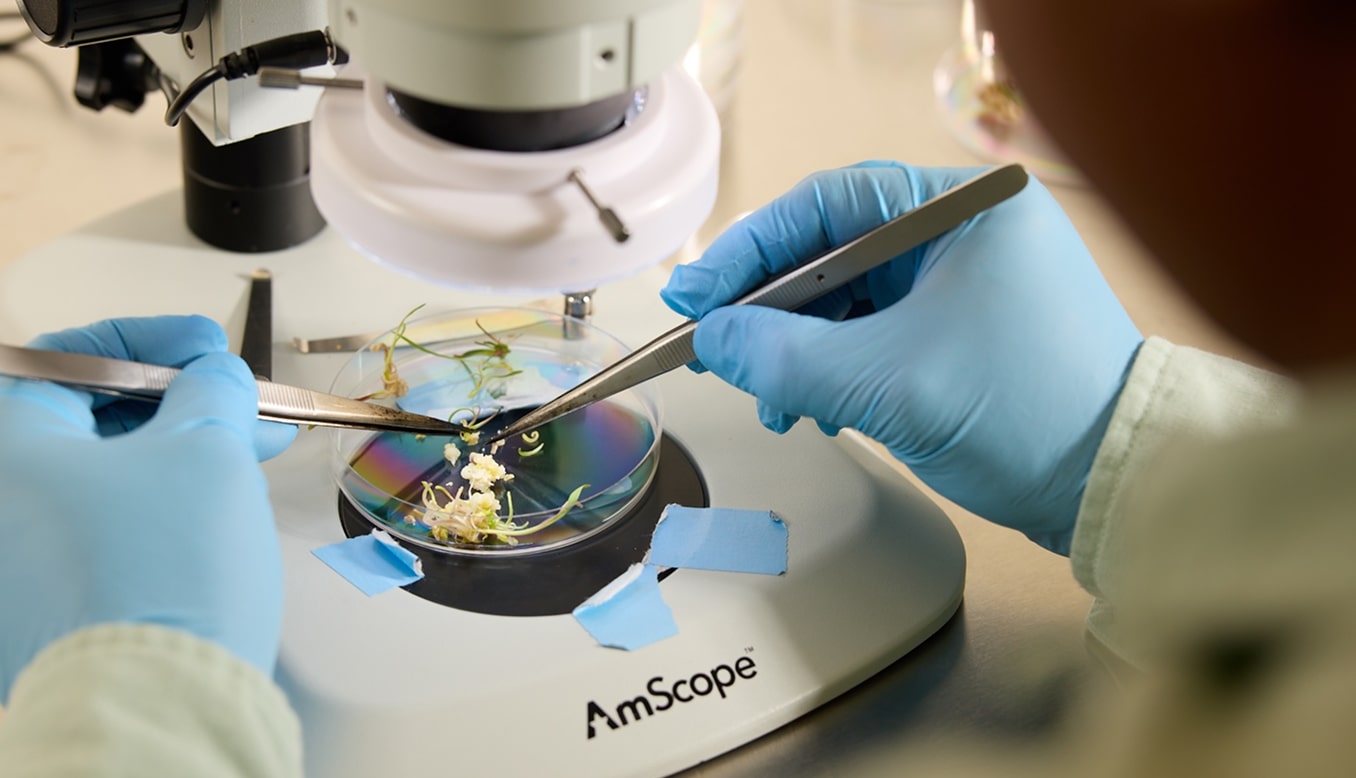

Your Trusted Agricultural
Research Partner










AgTech Innovation & Partnership
Solis brings deep industry knowledge, strategic partnership, and flexible solutions
Core Services
Plant Transformation & Editing
Services

Sequencing Services
Founded on Experience





Client Success Story
Collaboration Helps Advance Amfora’s Pipeline
Client Success Story
Solis Capabilities Advance Zeakal’s Proprietary Traits

Solis is proud to be a trusted partner with these and many other companies:



Testimonials
As a plant trait innovator, our growth roadmap and innovation pipeline would not be possible without Solis. The experienced team and world class capabilities, coupled with a deep understanding attuned to the needs of startups, is what makes Solis an indispensable partner. The team’s skilled hands and impeccable customer service have delivered results that consistently exceed our expectations.

Han Chen, CFA
Chief Scientific Officer ZeaKal
Solis is launching an exciting and new model for R&D services to support the expanding AgriFoodTech startup ecosystem. Meeting global challenges in climate, food security and sustainability requires new and improved crops. Solis will help scientists accelerate the discovery and commercialization of these important advances.

Rob Fraley
Former CTO, Monsanto & 2013 World Food Prize Laureate
I highly recommend Solis as a sequencing and genotyping partner for any kind of genomics work. In fact, I’ve already referred at least two research labs, and both were very happy with the pricing and data quality. It’s also always a pleasure to communicate with Solis. Their customer service is excellent, quick, and efficient.

Dongyan Zhao
Genomics Lead of Breeding Insight Cornell University
At Breeding Insight, we work with public plant and animal breeders who often face tight budgets and niche genomic data needs. Solis helped us get the most sequencing coverage for our fixed budget, and the flexibility of their WGS platform was a perfect fit. Hudson has been a tremendous help—working with him feels like having a coworker at Solis, someone truly invested in our success.

Moira Sheehan
Director of Breeding Insight Cornell University
As a plant trait innovator, our growth roadmap and innovation pipeline would not be possible without Solis. The experienced team and world class capabilities, coupled with a deep understanding attuned to the needs of startups, is what makes Solis an indispensable partner. The team’s skilled hands and impeccable customer service have delivered results that consistently exceed our expectations.

Han Chen, CFA
Chief Scientific Officer ZeaKal
Solis is launching an exciting and new model for R&D services to support the expanding AgriFoodTech startup ecosystem. Meeting global challenges in climate, food security and sustainability requires new and improved crops. Solis will help scientists accelerate the discovery and commercialization of these important advances.

Rob Fraley
Former CTO, Monsanto & 2013 World Food Prize Laureate
I highly recommend Solis as a sequencing and genotyping partner for any kind of genomics work. In fact, I’ve already referred at least two research labs, and both were very happy with the pricing and data quality. It’s also always a pleasure to communicate with Solis. Their customer service is excellent, quick, and efficient.

Dongyan Zhao
Genomics Lead of Breeding Insight Cornell University
At Breeding Insight, we work with public plant and animal breeders who often face tight budgets and niche genomic data needs. Solis helped us get the most sequencing coverage for our fixed budget, and the flexibility of their WGS platform was a perfect fit. Hudson has been a tremendous help—working with him feels like having a coworker at Solis, someone truly invested in our success.

Moira Sheehan
Director of Breeding Insight Cornell University
